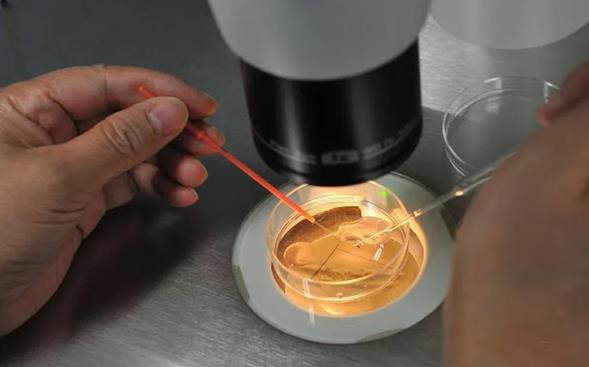

单身女性做试管婴儿费用需要多少钱?可以选择性别吗?
- 试管百科
- 2023-06-19 11:39
单身女性做试管婴儿费用需要多少钱?可以选择性别吗?很多单身女性一直未婚是常事,但是随着年龄的增长,生殖功能的下降也让很多女性开始焦虑。最近很多单身女性咨询边肖,问单身女性做试管婴儿要多少钱?可以自己选择性别吗?接下来592宝宝网小编将带您详细了解一下。
单身女性做试管婴儿费用需要多少钱?
1.检验费。如果患者没有其他影响成功率的疾病,则不需要调理和治疗费用。检查费用在2000-3000左右。
2.促排卵费。这包括医生的治疗费、b超费、药费、验血费等等。患者年龄越大,所需药物剂量越大,费用越高。这个阶段大概要花1.5-2万元。
3.取卵成本。大概2-5万,包括技术费用,医生会诊费用,胚胎移植费用。还有精子显微注射和胚胎培养的费用。
4.买精子的费用。通常买精子的费用在3000-5000之间。质量越好,越贵。
精子试管的费用受女性年龄、身体状况、治疗方案、选择的医院以及第三方精子价格的影响。所以每个人的总成本是不一样的。
选择权威医院做捐卵试管,会保证成功率和患者权益,不会乱收费。毕竟大医院的收费是严格按照物价局规定的标准收取的。不仅公开透明,而且价格合理,保证了手术过程中的安全性,大大提高了试管婴儿的成功率。
单身女性选择胎儿性别的条件:
1.患者患有X连锁隐性遗传病,如假性肥大性肌营养不良(DMD)、色盲、女性睾丸疾病、鱼鳞病、眼白化病、白化病、白化病、白化病、白化病、白化病、白化病等疾病。
2.患者患有X连锁显性遗传病,如维生素D抗性佝偻病、口面综合征、高氨血症I型、Alport综合征和色素障碍;
3.患者患有Y染色体AZFa、AZFb或AZFC缺失等Y连锁遗传病。
单身女性做试管婴儿费用需要多少钱?可以选择性别吗?以上就是关于单身女性做试管婴儿费用需要多少钱?可以选择性别吗?的全部内容。如果还有疑惑的话欢迎咨询592宝宝网试管资讯分享平台的专业生殖顾问。祝您好孕~

发表评论